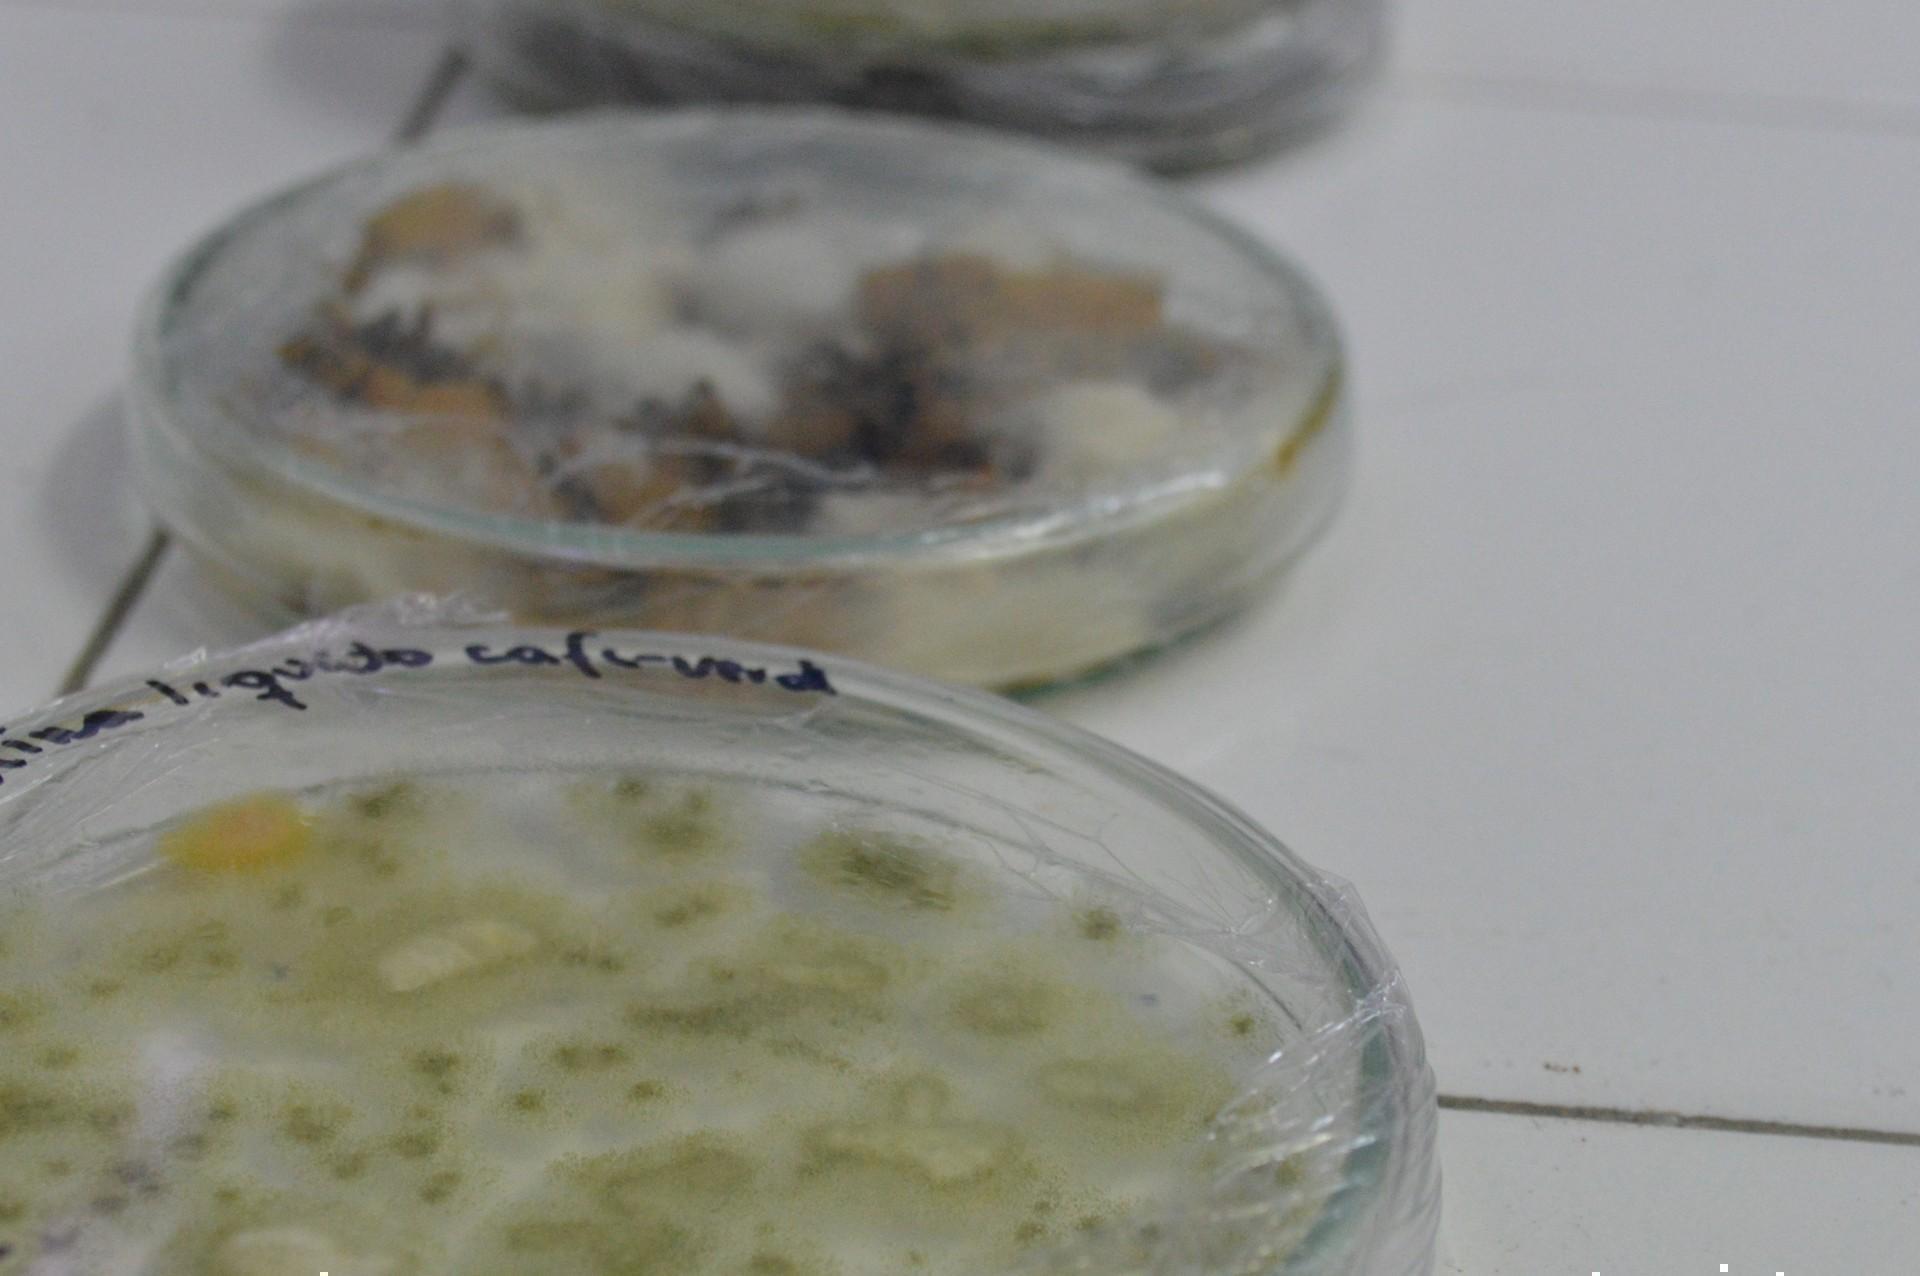
Agro

- ¿Qué estudiar?
Generación E
Haz parte de la Comunidad UPB en Medellín, Bucaramanga, Montería y Palmira.
- Sobre la Universidad
- Digitalmente juntos
- Autoevaluación Institucional Multicampus
- Sostenibilidad
- Sistema de Bibliotecas
- Identidad, Principios e Historia
- Directivos de la Universidad
- Centros, Institutos y Fundaciones
- Elecciones de representantes
- Normatividad y reglamentos
- Nuestra naturaleza y enfoque
- Información para la Dian
- Proceso de grados
- Visibilidad
Te puede interesar
- Nuestro Sistema
- Capacidades
¿Quieres investigar?
- Estudiantes UPB
- Estudiantes externos
Estudia con nosotros